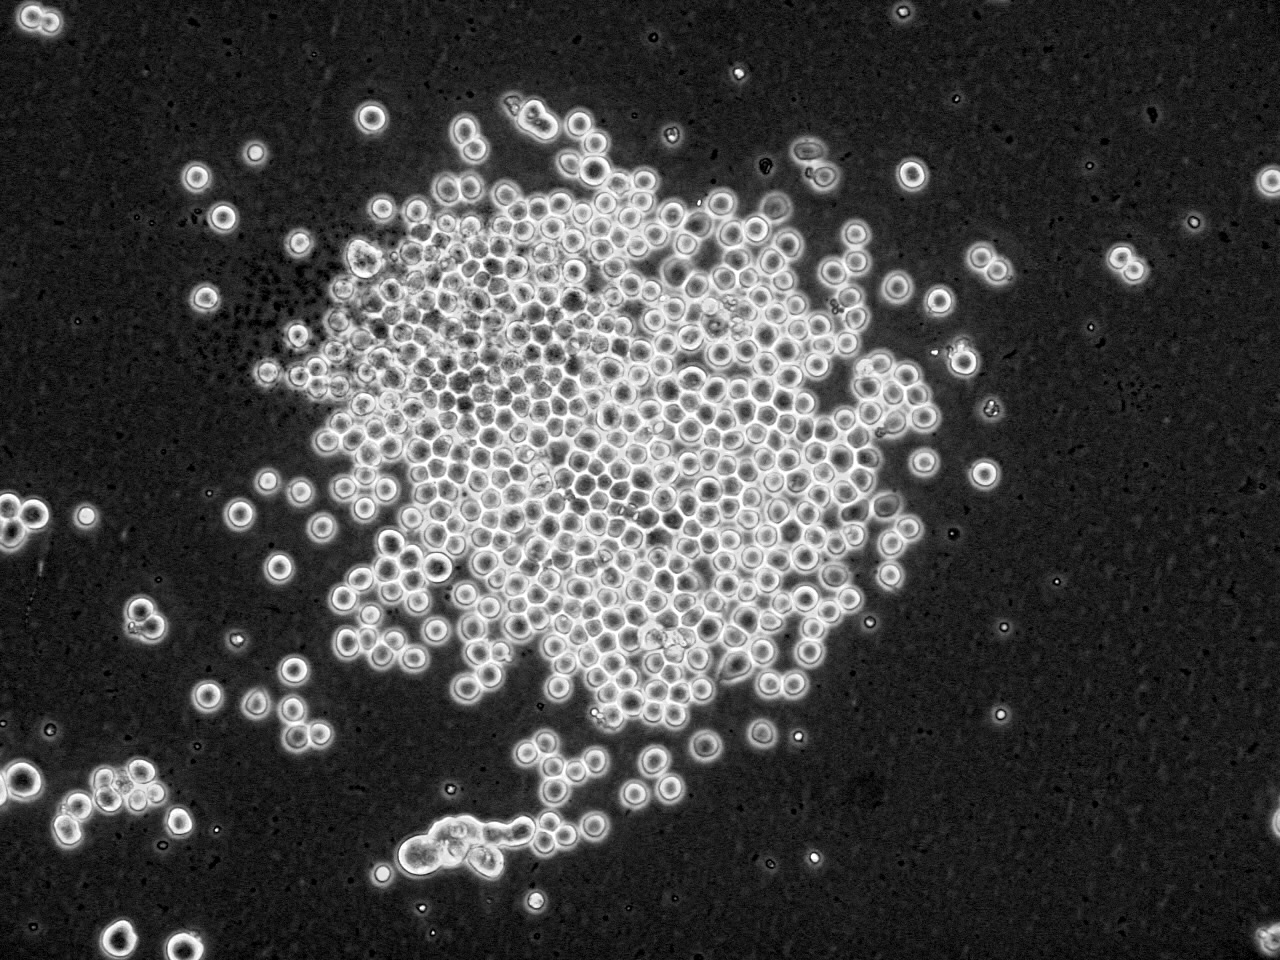

香港科技大學與北京綠竹生物製藥有限公司 首次利用昆蟲細胞生產蛋白研發戊型肝炎疫苗
香 港 科 技 大 學 ( 科 大 ) 與 北 京 綠 竹 生 物 製 藥 有 限 公 司 合 作 研 發 戊 型 肝 炎 疫 苗 , 首 次 利 用 獨 特 的 昆 蟲 細 胞 系 統 和 方 法 來 生 產 免 疫 原 蛋 白 , 為 影 響 全 球 三 分 一 人 口 的 傳 染 病 尋 求 預 防 方 法 。 這 項 世 界 首 創 的 疫 苗 技 術 由 科 大 生 命 科 學 部 謝 雍 教 授 帶 領 團 隊 研 發 , 能 簡 化 生 產 程 序 及 降 低 生 產 成 本 。
戊 型 肝 炎 ( Hepatitis E , 簡 稱 戊 肝 ) 又 稱 腸 道 傳 播 的 非 甲 非 乙 型 肝 炎 , 是 由 戊 肝 病 毒 ( HEV ) 引 起 , 該 病 可 呈 多 種 傳 播 方 式 , 包 括 : 日 常 接 觸 傳 播 : 通 過 被 污 染 的 手 和 器 具 , 或 直 接 與 口 接 觸 傳 播 ; 水 傳 播 : 水 源 被 污 染 所 致 ; 食 品 污 染 : 被 戊 肝 病 毒 污 染 的 食 品 , 特 別 是 未 煮 熟 的 蔬 菜 、 豬 內 臟 或 殼 類 水 產 品 ; 和 媒 介 傳 播 : 蒼 蠅 和 蟑 螂 可 充 當 傳 染 媒 介 , 使 食 品 受 到 污 染 。
戊 肝 在 世 界 範 圍 內 呈 散 發 分 佈 , 在 東 南 亞 、 北 非 與 中 非 、 印 度 及 中 美 洲 等 發 展 中 國 家 常 呈 爆 發 流 行 。 據 世 界 衞 生 組 織 估 計 , 全 球 三 分 之 一 的 人 口 曾 感 染 過 戊 肝 病 毒 , 在 南 亞 和 東 亞 每 年 約 發 生 650 萬 例 戊 肝 , 導 致 16 萬 人 死 亡 及 2,700 例 胎 兒 流 產 。 1986-1988 年 在 中 國 新 疆 曾 經 發 生 爆 發 流 行 , 共 發 病 119,280 例 , 707 人 死 亡 , 其 中 414 名 為 孕 婦 。 據 香 港 衞 生 防 護 中 心 報 道 , 2012 年 2 月 已 有 27 宗 感 染 戊 型 肝 炎 的 病 例 , 超 出 過 去 5 年 的 單 月 記 錄 , 表 明 戊 肝 在 成 人 急 性 肝 炎 中 發 病 率 居 首 位 。
戊 型 肝 炎 病 毒 ( HEV ) 感 染 是 一 個 重 要 的 公 共 衞 生 問 題 , 在 世 界 許 多 地 區 造 成 急 性 肝 炎 的 大 爆 發 。 研 發 出 有 效 預 防 戊 型 肝 炎 的 疫 苗 迫 在 眉 睫 , 北 京 綠 竹 生 物 製 藥 有 限 公 司 於 2010 年 5 月 和 香 港 科 技 大 學 研 究 開 發 公 司 簽 訂 了 合 作 開 發 研 製 戊 型 肝 炎 疫 苗 的 協 議 , 2010 年 9 月 啟 動 該 項 目 , 經 過 一 年 半 的 努 力 , 科 大 謝 雍 教 授 帶 領 的 團 隊 終 於 建 立 了 用 昆 蟲 細 胞 表 達 戊 型 肝 炎 病 毒 疫 苗 的 創 新 系 統 , 臨 床 前 研 究 工 作 正 在 按 計 劃 進 行 , 目 前 進 展 順 利 。 科 大 和 綠 竹 建 立 的 獨 特 表 達 系 統 和 方 法 , 能 夠 直 接 和 高 效 地 表 達 病 毒 抗 原 , 這 在 世 界 上 屬 首 創 , 並 且 由 於 產 生 的 抗 原 容 易 回 收 , 大 大 簡 化 生 產 程 序 , 降 低 生 產 成 本 , 得 到 更 能 被 廣 大 群 眾 所 接 受 的 產 品 。 它 的 特 點 是 用 昆 蟲 細 胞 能 夠 表 達 比 較 長 的 蛋 白 片 段 , 使 其 包 括 更 多 的 抗 原 決 定 簇 , 尤 其 是 T 細 胞 的 抗 原 決 定 簇 ; 昆 蟲 細 胞 表 達 的 蛋 白 折 疊 方 式 更 接 近 於 天 然 蛋 白 , 這 些 優 點 都 表 明 其 表 達 的 蛋 白 免 疫 原 性 較 強 。
為 了 早 日 開 發 該 疫 苗 , 團 隊 成 員 包 括 科 大 與 綠 竹 研 發 成 員 夜 以 繼 日 的 工 作 , 已 克 服 了 許 多 困 難 取 得 了 目 前 的 成 果 。 該 項 研 究 可 取 得 自 主 知 識 產 權 , 並 為 人 類 肝 炎 預 防 控 制 做 出 貢 獻 。
傳 媒 查 詢 :
葉 潔 明
電 話 ﹕ 2358 6313
電 郵 ﹕ kityip@ust.hk